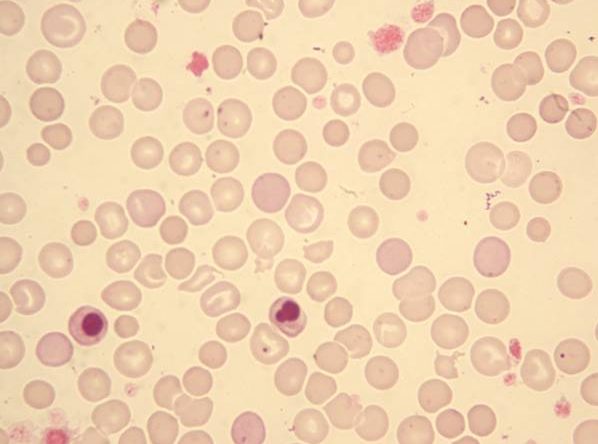

Small Animal Practice Club
Coming up in Small Animal Practice Club
- June 2026
Lapraroscopy with Matteo Rossanese - July 2026
New Graduate Dentistry Basics with Charlie Tewson - August 2026
Staging and Oral Biopsy Technique with Andrew Perry - September 2026
Immune Mediated Skin Conditions with Jon Hardy - October 2026
Mammary Tumours with Owen Davies - November 2026
Cryptorchid Surgery with Tom Hernon - December 2026
Syringomyelia with Clare Rushbridge
Over 100 hours of content immediately available to new members
View Archives Monthly Membership£75 plus VAT Annual Membership
£797 plus VAT
Coming up in Small Animal Practice Club
- June 2026
Lapraroscopy with Matteo Rossanese - July 2026
New Graduate Dentistry Basics with Charlie Tewson - August 2026
Staging and Oral Biopsy Technique with Andrew Perry - September 2026
Immune Mediated Skin Conditions with Jon Hardy - October 2026
Mammary Tumours with Owen Davies - November 2026
Cryptorchid Surgery with Tom Hernon - December 2026
Syringomyelia with Clare Rushbridge
Over 100 hours of content immediately available to new members
View Archives Monthly Membership£75 plus VAT Annual Membership
£797 plus VAT